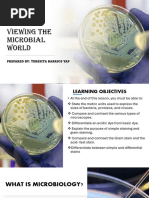

0% found this document useful (0 votes)
178 views48 pagesMicroscopy Lecture 2024
A microscope is a magnifying instrument used to enlarge small objects, commonly utilized in clinical laboratories. It consists of various systems including support, magnification, illumination, and adjustment systems, with different types such as bright field, phase contrast, and fluorescence microscopes. Proper care and usage are essential, including routine maintenance and understanding the functions of its components for effective operation.
Uploaded by
Angelina HumanCopyright
© © All Rights Reserved
We take content rights seriously. If you suspect this is your content, claim it here.
Available Formats
Download as PPT, PDF, TXT or read online on Scribd
0% found this document useful (0 votes)
178 views48 pagesMicroscopy Lecture 2024
A microscope is a magnifying instrument used to enlarge small objects, commonly utilized in clinical laboratories. It consists of various systems including support, magnification, illumination, and adjustment systems, with different types such as bright field, phase contrast, and fluorescence microscopes. Proper care and usage are essential, including routine maintenance and understanding the functions of its components for effective operation.
Uploaded by
Angelina HumanCopyright
© © All Rights Reserved
We take content rights seriously. If you suspect this is your content, claim it here.
Available Formats
Download as PPT, PDF, TXT or read online on Scribd